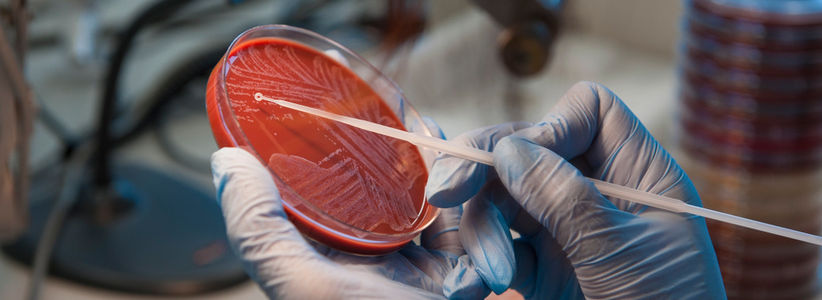
Speciality Group’s second webinar promises wide spectrum of discussion next month

Speciality Group’s second webinar promises wide spectrum of discussion next month
The NHS Research Scotland (NRS) Reproductive Health and Childbirth Specialty Group has announced its second quarterly webinar taking place next month with two guest speakers exploring diverse areas of new learning
Taking place on Wednesday 19 November from 12.10-1pm, the informal session — entitled ‘Mismatch in Testing in Endometrial Cancer and Lynch Syndrome Diagnosis; and Learn More About VPAG in Scotland’ — will be hosted live on Microsoft Teams.
The bitesize ‘lunch and learn’ webinar will be opened by the Specialty Group’s Champion Support Manager, Annie Ganguly, and chaired by Dr Lucky Saraswat, Consultant Gynaecologist and minimal access surgeon at Aberdeen Royal Infirmary.
Dr Saraswat is the Lead for the Aberdeen Endometriosis Centre which provides tertiary care services for endometriosis patients in the North and North East of Scotland.
The webinar will be hosted live on Microsoft Teams and will welcome wide-ranging guest speakers:
- Dr Neil Ryan, RCOG Subspecialty Trainee in Gynaecological Oncology at the Royal Infirmary of Edinburgh and a CSO/NES Clinical Lecturer at the University of Edinburgh. His research focuses on the molecular determinants of cancer risk and treatment response, with a particular interest in mismatch repair deficiency (MMR-D). Dr Ryan leads the EU PREDI-Lynch Gynaecology arm and is developing translational trials to improve personalised care in endometrial and other Gynaecological cancers
- Sarah Kennedy, Scotland’s VPAG Network Manager, who facilitates and supports the delivery of the Voluntary Scheme for Branded Medicines Pricing, Access and Growth (VPAG) Investment Programme activities. She has more than 15 years’ experience in Research & Development, and prior to this role, was based in NHS Tayside as a Portfolio Manager, responsible for six NRS Specialty areas
Dr Ryan will focus on research around when initial tumour testing for MMR-D does not lead to a confirmed Lynch Syndrome diagnosis due to gaps in the diagnostic pathway, while Sarah will present an overview of the VPAG Investment Programme in Scotland.
Both segments will offer time for Q&A.
Annie said: “We are pleased to be offering such a wide-ranging webinar under the vital collective umbrella of groundbreaking research which impacts reproductive health and childbirth, and I’m proud to have the opportunity of welcoming such knowledgeable guests to share their unique insights.
“Continuing the momentum created by our first session in September, this one will allow Neil to expand on his interest in, and findings around, MMR-D – linked to an increased risk of certain cancers, such as colorectal, endometrial, and breast cancer.
“Sarah will meanwhile tell us about how VPAG is building on the existing strengths of the country’s clinical research support infrastructure to provide a globally competitive ‘once for Scotland’ delivery network for commercial trials.
“We are also of course extremely grateful to endometriosis expert Lucky for chairing the webinar, helping to ensure good speaker and attendee interaction.”
The ongoing webinar series is dedicated to advancing understanding and dialogue around reproductive health, pregnancy, and childbirth through a research-focused lens with further speakers being invited to shape its topics and themes.
The speciality group is continuing to welcome submissions from researchers, clinicians, midwives, students, educators, public health professionals, and more.
Planned webinar dates to follow are:
- Wednesday 18 February
- Wednesday 17 June
The series aims to highlight current evidence, emerging studies, and critical gaps in knowledge across topics such as fertility, maternal and foetal outcomes, respectful maternity care, perinatal mental health, postnatal recovery and much more related to this area of health care.
If you are interested in presenting your work, suggesting topics, or collaborating on future webinars, please contact Champion Support Manager, Annie Ganguly.
Publication date: 27th October 2025

